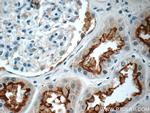
TMEM38B Antibody in Immunohistochemistry (Paraffin) (IHC (P))

Search
Proteintech
TMEM38B Polyclonal Antibody
{{$productOrderCtrl.translations['antibody.pdp.commerceCard.promotion.promotions']}}
{{$productOrderCtrl.translations['antibody.pdp.commerceCard.promotion.viewpromo']}}
{{$productOrderCtrl.translations['antibody.pdp.commerceCard.promotion.promocode']}}: {{promo.promoCode}} {{promo.promoTitle}} {{promo.promoDescription}}. {{$productOrderCtrl.translations['antibody.pdp.commerceCard.promotion.learnmore']}}
产品信息
19919-1-AP
种属反应
宿主/亚型
分类
类型
抗原
偶联物
形式
浓度
规格
纯化类型
保存液
内含物
保存条件
运输条件
产品详细信息
Immunogen sequence: ERLVKGDWK PEGDEWLKMS YPAKVTLLGS VIFTFQHTQH LAISKHNLMF LYTIFIVATK ITMMTTQTST MTFAPFEDTL SWMLFGWQQP FSSCEKKSEA KSPSNGVGSL ASKPVDVASD NVKKKHTKKN E (162-291 aa encoded by BC000049)
靶标信息
TMEM38A and TMEM38B are two recently identified trimeric intracellular cation (TRIC) channel subtypes. TMEM38B is expressed in most mammalian tissues, while TMEM38A is preferentially expressed in excitable tissues such as striated muscle and brain. Mice deficient in both TMEM38A and TMEM38B suffer embryonic cardiac failure; the cardiac myocytes display severe dysfunction in SR Ca2+ handling, weakened Ca2+ release, and reduced K+ permeability indicating that the TRIC cation channels are likely to act as counter-ion channels that function in synchronization with Ca2+ release from intracellular stores. Mice that were lacking only TMEM38B however, die shortly after birth due to respiratory failure and have lungs exhibiting severe histological defect and ultrastructural abnormalities in their alveolar type II epithelial cells, indicating that TMEM38B are essential for perinatal lung maturation. Other experiments have shown that TMEM38A and TMEM38B can act with junctophilin proteins to support efficient ryanodine receptor-mediated Ca2+ release in muscle cells.
仅用于科研。不用于诊断过程。未经明确授权不得转售。
篇参考文献 (0)
生物信息学
蛋白别名: FLJ10493; Mitsugumin-33B; Mitsugumin33B; RP11-219P18.1; Transmembrane protein 38B; TRIC-B; TRICB; Trimeric intracellular cation channel type B; unnamed protein product
基因别名: 1600017F22Rik; AA437809; AV051057; bA219P18.1; C9orf87; D4Ertd89e; Mg33b; OI14; TMEM38B; TRIC-B; TRICB
UniProt ID: (Human) Q9NVV0, (Mouse) Q9DAV9
Entrez Gene ID: (Human) 55151, (Mouse) 52076